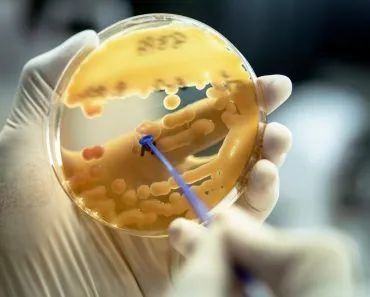
Klebsiella,Pneumoniae,Colonies;,Close,Up,The,Media,Plate,On,Hand

Plastic-degrading bacteria are a possible future solution to the growing crisis surrounding plastic pollution. The high molecular weight polymer is very sturdy and difficult to decompose, but not impossible, if the right techniques are applied.
While you might be thankful for sturdy ketchup bottles that don’t shatter when they hit the ground, you might not be as happy to learn that the same bottle could take more than 400 years to decompose.
We use plastic so often that it’s almost impossible to imagine life without it. Gone are the days when we could get milk in a glass bottle; it seems like everything today comes in some form of plastic.
And why wouldn’t that be the case? Plastic has long been convenient, sturdy, flexible, resistant to wear & tear, and often the most inexpensive alternative to glass.
Well, that’s no longer the modern perspective. You are likely aware of our increasing need to collectively curb the use of non-recyclable plastic because they don’t decompose easily, representing another side of our climate and sustainability crisis.

Recommended Video for you:
Types Of Plastic
Plastic comes in many types, including PET (polyethylene terephthalate) and polyethylene. These are the most commonly found plastics in household items and also some of the hardest to decompose.
Fortunately, there might be some hope from nature’s old-school and most reliable organisms—bacteria.
Before we understand how bacteria might help solve our problem, let’s begin with what makes plastic so indestructible.
Why Is Plastic So Hard To Decompose?
Plastic is a man-made synthetic substance composed of different elements, including carbon, hydrogen, oxygen, nitrogen and chlorine. It is a high molecular weight polymer made of repeating units of monomers.
The byproducts of petroleum are an important raw material in plastic manufacturing. Polyethylene or polythene is the most common byproduct, and is responsible for the non-biodegradable nature of plastics.
During the formation of plastic, several monomeric units of ethylene or propylene, for example, join and bind together with the help of strong hydrogen forces. Such forces are almost impossible to break, rendering the end-product plastic close to indestructible.
The reason for this is simple: petroleum itself is the product of millions of years of decay by microorganisms. Thus, it makes sense that petroleum-derived products take a long time to decompose. Naturally-occurring bacteria are seldom able to comprehend the nature of such complex compounds and are therefore unable to degrade it.
Is It Possible To Degrade Plastic?
This question has haunted scientists and environmentalists around the globe for a very long time. The growing production of and demand for plastics, coupled with its innate nature of being darn close to immortal, has earned experts and scientists some severe criticism. Many methods of plastic degradation are implemented today, but the complete elimination of plastic remains a distant possibility.
The most common forms of plastic degradation include exposure to UV (ultraviolet) light, together with mechanical destruction caused by wind or waves. The process eventually breaks larger plastic materials into smaller pieces, which are called nano- and microplastics. A microplastic is less than 5 mm in size, while a piece of nanoplastic is something less than 0.1 micrometer.

Plastics can be degraded to a certain extent by using mechanical methods but the end-products such as micro and nano-plastics find their way into the marine and terrestrial ecosystem.
These tiny fragments are mistaken as food and are consumed by marine and terrestrial animals and ultimately enter the food chain. A study done on the fish Acanthochromis polyacanthus revealed that micro-plastics of dimensions greater than 300 micrometers were present in the gut-cavity of the fish.
Not only fishes but terrestrial animals like sheep or goat might consume micro or nano-plastics inadvertently. As the animal isn’t able to completely digest the plastic it gets accumulated in its digestive system. This plastic eventually enters the human body when the digestive system of such animals is consumed. Plastics contain several toxic components including carcinogens, lead, cadmium and mercury and can cause enormous damage when ingested.
The current mechanical methods to degrade plastic are insufficient as they cannot completely degrade plastics. Here’s where microorganisms come into action due to the variety of enzymes present in them.
Plastics have seen phenomenal growth in their manufacture and use since their introduction in 1960. Nature isn’t able to cope with such a rapid increase in the use of plastic. As a result, most of nature’s bacteria haven’t completely evolved with the enzymes capable of degrading plastic completely.
Plastic Degrading Bacteria
As the old saying goes, where there’s a will, there’s a way. In 2016, a team of researchers of the Kyoto Institute of Technology first identified a bacterium (plural: bacteria) Ideonella sakaiensis. The bacterium was found at one of the PET bottle recycling facilities in Japan and it could provide the plastic-degrading qualities that humanity needs!

This isn’t the only bacterium that can accomplish this once-impossible feat. There are a few others that can also reduce the polymeric plastic into oligomers (8 monomeric units) and monomers.
Bacteria belonging to the phylum Actinobacteria and genera Thermobifidia, Thermomonospora and Saccharomonospora have given some promising results with their plastic-degrading enzymes. There are many more bacteria that can degrade plastic but the enzymes present in them are slow for industrial use. There is still a lot of research to be done before bacteria can be used on a large scale.
How Do Microorganisms Degrade Plastic?
Ideonella sakaiensis is the best-studied model to demonstrate how bacteria can reduce plastic.
Polyethylene terephthalate (PET) and polystyrene are the most commonly used household plastics. When I. sakaiensis comes into close contact with PET surfaces, the bacterium uses a secreted hydrolase enzyme or PETase to degrade PET.

An enzyme is a biological catalyst that can speed up chemical reactions. A hydrolase reaction is any reaction that uses a water molecule to break down a chemical bond.
In short, a PETase reaction is an enzymatic reaction involving the breakage of a carbon bond with the help of a water molecule. PET is the major carbon and energy source for the bacterium.
PETase degrades PET into mono (2-hydroxyethyl) terephthalic acid (MHET) and ethylene glycol. Both of these end products are comparatively benign and easier to degrade with simpler methods. MHET is degraded into 2 monomeric compounds by the cell’s outer membrane, while Ethylene glycol is readily taken up and used by I. sakaiensis and other surrounding bacteria.
Four enzymes from the bacterium Thermobifidia have been identified as potent PET degraders. There are certain limitations, as the enzymes are partially inhibited by the intermediate MHET product. Efforts are being made to overcome this obstacle.
Polyethylene (PE) or polythene is a long-chain polymer of ethylene monomers that is the target of microorganisms for degradation. Several bacteria can degrade PE, including Pseudomonas, Staphlyococcus, Streptomyces, etc. Some fungal species are also assumed to degrade PE, such as Aspergillus, Cladosporium, Penicillium and various others.
The use of the above-mentioned bacteria and fungi for degrading PE plastics is still in the research stage and we are awaiting concrete evidence about its efficacy and potential for the future.
Conclusion
The idea of plastic-degrading bacteria is surely a ray of hope in a potentially dark and plastic-filled future, but there is still a lot to be considered. The problem lies with plastics’ high molecular weight structure. Its initial breakdown is the hurdle that needs to be crossed. There might be many enzymes that can break down plastic quickly, but the technology to develop and identify them is still in nascent stages. One such promising source is the use of metagenome data sets.
Metagenomics is the study of genetic material that is recovered directly from a source. Most of the scientific research that is done involves studying pure microbial cultures. At times, this reduces the understanding of how these isolated microbes react with other microbes in their natural habitat.
Metagenomics fills this gap and provides a means for studying microbes on their “home turf”. This method might have the potential to reveal new types of microbes that live in surroundings similar to Ideonella sakaiensis.
While this might sound like an easy and obvious solution to our plastic problem, there is still a lot of research that must be done. The only thing we can do as individuals is to make a conscious effort to reduce our plastic use. This small step, though it can seem insignificant, may be a great benefit for us and all future generations on the planet!
References (click to expand)
- Danso, D., Chow, J., & Streit, W. R. (2019, October). Plastics: Environmental and Biotechnological Perspectives on Microbial Degradation. (H. L. Drake, Ed.), Applied and Environmental Microbiology. American Society for Microbiology.
- Geyer, R., Jambeck, J. R., & Law, K. L. (2017, July 7). Production, use, and fate of all plastics ever made. Science Advances. American Association for the Advancement of Science (AAAS).
- Petroleum-Based Polymer - an overview | ScienceDirect Topics. ScienceDirect
- (2022) Why Metagenomics? - The New Science .... The National Center for Biotechnology Information
- Chatterjee, S., & Sharma, S. (2019). Microplastics in our oceans and marine health. Field Actions Science Reports. The Journal of Field Actions, (Special Issue 19), 54-61.